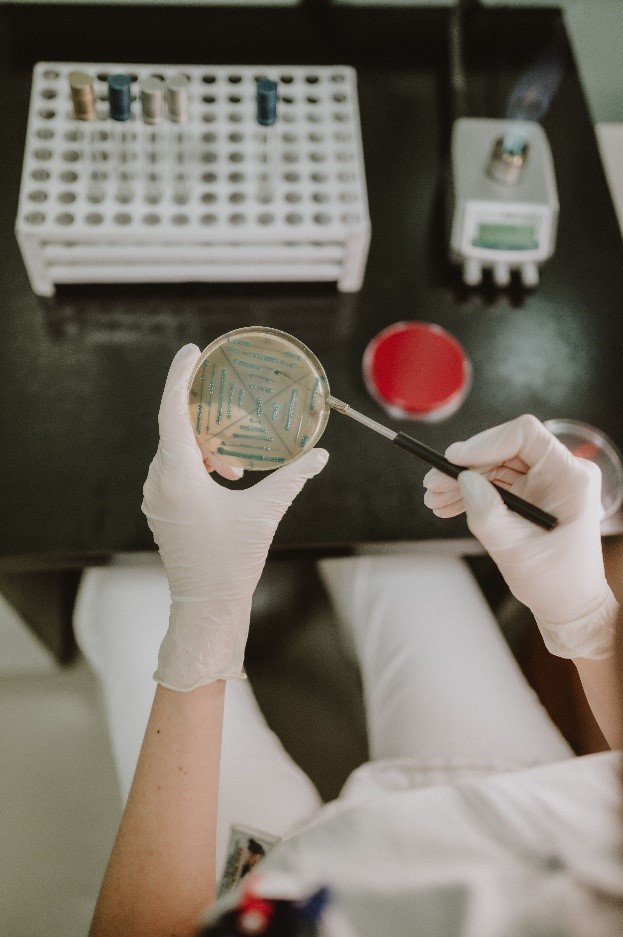

Project overview
Joint central European actions for improving quality of urban bathing waters
When it’s hot in summer there is nothing better than taking a swim. However, in central European cities this might not be a good idea: 65% of urban surface waters meet only minimum quality standards. The project UrbanBlueHealth improves this condition by first assessing health impacts and then creating new solutions for cleaning up urban lakes and rivers. Amongst others, the partners develop a Blue Health Repository for monitoring and test it in pilots. Water site managers and urban beach operating bodies are trained to implement action plans, and a digital platform makes the new solutions available to other cities.
-
1,63m €
-
Project Budget
-
80%
-
of the Budget is funded by ERDF
-
5
-
Countries
-
8
-
Regions
-
9
-
Partners
-
3
-
Pilots
Duration
Start date
End date
Project progress
About the project
Project partnership
Project partners

Lead partner
National Center for Public Health and Pharmacy
Department of Public Health, Laboratories and Methodology
Project partner
Chemical Safety Department/Biological Safety Unit
Department for Water Safety and Supply
CePII, Institute for Hygiene and Applied Immunology, Unit Water Hygiene
Department of Public Health
Roadmap
News
Events
Pilot actions
Outputs
Joint CE Transnational Bathing Water Strategy
Urban Bathing Water Action Plans
Solutions on improving urban bathing sites
Project documents
UrbanBlueHealth – Related Websites, Partners, and Media Articles
Historic travel back in time
Solutions and even more
UrbanBlueHealth
The project lead partner is responsible for the content of this project website.





















